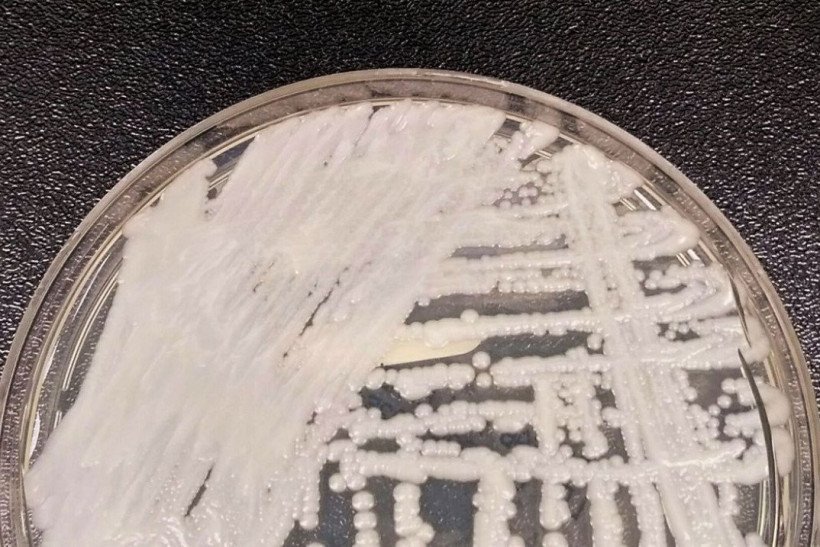
Confirmado segundo caso de Candida auris em Pernambuco

Paciente infectado por superfungo morre em Belo Horizonte
A Secretaria de Estado de Saúde descartou que a morte tenha relação com a infecção, uma vez que estava internado em virtude de grave acidente com moto
postado em 16:46 - 17/10/2024
A Secretaria de Estado de Saúde descartou que a morte tenha relação com a infecção, uma vez que estava internado em virtude de grave acidente com moto
postado em 16:46 - 17/10/2024
Desde maio deste ano, 11 pessoas foram diagnosticadas com a doença no estado. De acordo com a Secretaria de Saúde, a morte deste terceiro paciente foi provocada por outros problemas de saúde que não têm relação com o fungo
postado em 22:03 - 19/07/2023
Homem foi internado com lesão na perna antes de descobrir superfungo Candida auris. Unidade suspendeu novos atendimentos para monitoramento
postado em 18:13 - 05/07/2023
O fungo foi detectado no dia 18 de maio, em um paciente recém-nascido que não teve a identidade revelada. Ele está recebendo tratamento e acompanhamento médico
postado em 16:17 - 08/06/2023
O Candida auris causa infecção na corrente sanguínea e outras infecções invasivas e é muito resistente aos medicamentos normalmente usados para combater fungos
postado em 16:30 - 29/05/2023
Três casos do superfungo foram identificados em três municípios de Pernambuco e colocou em alerta Secretaria Estadual de Saúde. Nos EUA, o fungo é visto como ameaça "alarmante"
postado em 12:32 - 24/05/2023
O "superfungo", como vem sendo chamado, pode ocorrer em unidades hospitalares e é multirresistente, de difícil erradicação e identificação
postado em 14:24 - 22/08/2022
A levedura – tipo de fungo que possui apenas uma célula – causa grande preocupação nas autoridades sanitárias por ser resistente à maioria dos fungicidas existentes
postado em 09:23 - 16/01/2022
Os dois pacientes, um homem de 38 anos e uma mulher de 70 anos, foram isolados no início do mês
postado em 23:38 - 13/01/2022
O micro-organismo apresenta resistência a medicamentos e a produtos de limpeza. Outro fator é a dificuldade de identificação laboratorial do patógeno. Entre os principais problemas da doença estão a infecção da corrente sanguínea e outras complicações invasivas
postado em 18:56 - 13/01/2022